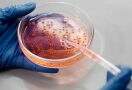

Rio Grande do Sul Governador sanciona projeto de lei que desburocratiza processos administrativos no RS
Por Redação O Sul | 6 de maio de 2021

A nova lei, sancionada no Palácio Piratini, deve entrar em vigor dentro de 90 dias.
Foto: Felipe Dalla Valle/Palácio PiratiniO governador Eduardo Leite sancionou, na tarde desta quinta-feira (6), o Projeto de Lei 127/2020, que regulamenta os processos administrativos em todos os Poderes do Estado. A medida pretende gerar a desburocratização de práticas administrativas – facilitar a tramitação e a realização de atos processuais por meio de ferramentas digitais – e, sobretudo, promover mais transparência ao cidadão e segurança jurídica a possíveis investidores.
Leite anunciou, ainda, que será criado um grupo de trabalho, por decreto, para estabelecer a regulamentação da agora lei, que deve entrar em vigor dentro de 90 dias.
“A vida das pessoas e das empresas se acelerou, e o governo não pode ficar preso a formas e formatos. Formas e formatos são importantes, por questões de processo e transparência, mas desde que não se evite as evoluções que se impõem diante das inovações tecnológicas. Nesse sentido se dá a importância de digitalizar, desburocratizar e uniformizar os processos administrativos do Estado. Algo que está no meio, não na finalidade do poder público, mas um meio fundamental sem o qual as finalidades da atividade pública não se cumprem”, pontuou o governador.
O procurador-geral do Estado, Eduardo Cunha da Costa, destacou que agora o Rio Grande do Sul deixa o rol dos Estados sem lei do processo administrativo e ingressa no dos que têm os sistemas processuais mais modernos.
Costa frisou ainda que a nova legislação garantirá maior segurança jurídica aos cidadãos, a partir de procedimentos dotados de transparência, uniformidade e previsibilidade, propiciando um ambiente desburocratizado e com soluções céleres e seguras para as demandas da sociedade.
O texto do PL, que foi aprovado por unanimidade no dia 13 de abril, teve origem no projeto estratégico RS Uniforme, lançado pela PGE (Procuradoria-Geral do Estado) em abril de 2019. Um grupo de trabalho avaliou as necessidades para elaborar a base do projeto, que foi acolhida pela gestão da PGE.
Na Assembleia Legislativa, a temática relacionada ao processo administrativo teve início, também em 2019, com o protocolo de projeto apresentado pelo deputado Ernani Polo. Após, a matéria seguiu com a proposição do deputado Gabriel Souza, atual presidente do Parlamento gaúcho. Em articulação com o governo do Estado, substituiu a proposta inicial pela construída pela PGE.
“Foi um trabalho feito a muitas mãos, do Legislativo e do Executivo, construindo um projeto de lei que vem ao encontro do interesse público para atualizar a gestão pública ao momento que vivemos. Por isso, hoje, é um dia realmente de comemoração”, afirmou Souza.
O deputado destacou, ainda, que o texto incorpora instrumentos trazidos pela Lei Estadual 15.431, que instituiu a Declaração Estadual de Direitos da Liberdade Econômica.
Voltar Todas de Rio Grande do Sul